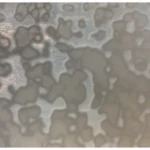
UROBOROS - WHITE RING MOTTLE

Ajouter un avis
UROBOROS - WHITE RING MOTTLE
UROBOROS - WHITE RING MOTTLE
Votre avis
* Review is required
Nom
* Name is required
Courriel
* Email is required
Ajoutez des photos ou une vidéo à votre avis
* Please tick the checkbox to proceed






Avis
Il n’y a pas encore d’avis.